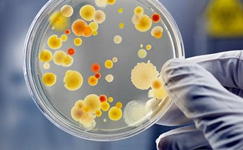
microbiological-testing-fb.jpg microbiological-testing-fb.jpg

Food and beverage analysis
Quality control is essential in food and beverage production to ensure consistent products that are safe for human consumption. This control can involve different types of analyses, such as identifying microbes, testing physical and chemical properties and detecting contamination by toxins, pesticides, drug residues and more. Avantor® offers the products you need to analyze your food and beverage samples.
Microbiological Testing
Identify potential contamination in food or beverage products with pathogenic microorganisms.
3M offers a range of products to simplify microbiological analysis of food and beverage samples.
Whether you need a magnifier, microscope or stereo microscope to control macro contamination in your product, you can find it here.
Physical Testing
Current quality standards require objective colour measurements in daily lab routines.
The melting point is a useful value in determining the quality and purity of food ingredients. It can also be used to differentiate between vegetable and animal oils and fats.
We offer many density measurement systems, from hydrometers, pycnometers and balances to instruments for rapid density analysis.
Refractometry is a basic method for quantitative analysis and quality assurance methods in the food and beverage industry.
Viscosity is an important quality indicator for food and beverages because it can affect packaging and quality perception.
Weigh your product using scales with a percentage weighing feature or balance indicator to easily determine whether the measurement is in the tolerance zone.
Chemical testing
Avantor® offers a large selection of systems to measure the different elements of food and beverage samples, including test strips, visual kits, portable colorimeters, photometers, bench photometers and spectrophotometers.
Kjeldahl determination is a commonly used method to determine the amount of protein in food.
Measuring water content is a prevalent technique in food and beverage production processes. The most used method is Karl Fischer titration, but other methods, such as loss on drying (LOD), are also used.
We offer a choice of moisture analyzers with infrared or halogen heating and ceramic or coiled quartz elements for routine and precision measurements.
We are the largest distributor of electrochemistry resources, offering the best choice of well-known suppliers and products.
Everything you need for this routine quantitative technique, from classical glassware to automatic titrators, reagents and accessories.
Measuring the concentration of salt (sodium chloride) in foods and beverages is a universal requirement in industrial production. The Sherwood Scientific M926 Chloride Analyzer is ideal because it can directly read the salt concentration.
Find the chemicals, consumables, kits and instruments that you need to analyze edible oils and fats.
Chromatographic separations are widely used for developing and manufacturing food and drink products, particularly for the more recent developments of functional foods. HPLC and GC are widely employed to ensure consumer safety.
Meat speciation is the identification of the animal species that a piece of meat came from and is performed for various economic, ethical, cultural and safety reasons.
HPLC requires using flammable liquids, which must be stored safely. Check out our range of safe storage systems.
Other analyses
Ready-to-use and tailor-made products for your applications in the food and beverage industry.
Pesticide residues could end up in food or beverage products and have harmful effects. Screen for contamination with these standards from Merck.
A full range of fat- and water-soluble vitamins for use in various chromatographic, mass spectrometry-based and other analytical applications.
Standards for allergens, antioxidants, flavors, fragrances, sweeteners, organic acids and more.
Rapid screening for common allergens such as egg whites, peanuts, soy, walnuts and more. Detects both processed and unprocessed allergens.
Have questions about analyzing food and beverage samples?
Contact us today to discuss your needs. Our team is ready to help.